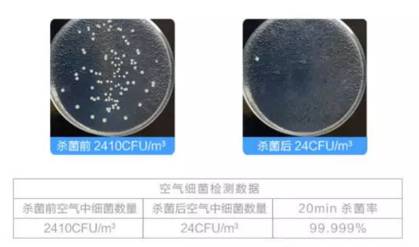
关键时刻，一套解决所有烦恼！

大家家里有没有常备一个医药箱?
生活中总会有一些小磕碰小伤口:切菜不谨慎切到了手指,打球不留神扭伤了脚,吃东西上火口腔溃疡,春季花粉过敏喷嚏不断,孩子不谨慎被烫伤等等。
如果没自备一个医药箱,每次出点小状况,要么默默忍受,要么只能跑到医院排长队了。。。


德国进口丨个护名牌丨必备药箱
SOS个人护理套装


SOS 是德国国民药妆品牌,研发的护理产品,深受欧洲家庭长期信赖。产品覆盖率高达 95%,在欧盟各大商场超市都有出售~

SOS 2016年获得了德国国家品牌大奖,被誉为“德国科技护理的典范”。

前方高能
今天给大家带来的SOS个护套装有:



能有效杀灭HIV的随身消毒喷雾!
淡化修护疤痕的疤痕修复膏!
比日本小林还好用的液体创可贴!

日常生活中,难免一些小磕碰小伤口,尤其是熊孩子,活蹦乱跳的,冷不丁就头破血流了。。
通常,我们会使用这样的普通创可贴。

但这个创可贴最大的缺点,就是不能长时间使用 。
不然皮肤不透气,还可能会加重伤口和伤口周围皮肤的感染。

而 SOS 的这款液体创可贴只需轻轻一喷,不仅能止血,还能消毒杀菌。
仅需30秒即可形成一层透明,透气的保护膜。

这层保护膜不仅防水透气,还能加速愈合,洗澡也不怕影响伤口的恢复~割伤、划伤和擦伤、轻微烧伤、晒斑、蚊虫叮咬、开水泡这些日常小伤都不在话下。

国家队指定的产品为他们保驾护航,怪不得德意志战车那么猛~


再举个例子~

不仅仅是免洗洗手液,还是全能的消毒水。
如厕后手喷一喷,睡前被子喷一喷,牙刷消毒喷一喷,手机喷一喷。100ml 的容量还能方便携带。
实验证明,20min杀菌率高达99.9%,值得信赖!

春季气候温和湿润,更是细菌繁殖传播的猖狂时期。诸如各类流感,甲肝,乙肝,艾滋病,手足口病等等让人防不胜防。
SOS随身免洗消毒喷雾,医用级别的防护,能有效灭杀流感病毒、流行性肝炎毒,HIV等绝大部分包膜病毒。
这款 SOS 随身消毒喷雾可用于所有人群,特别适用于婴幼儿和大部分过敏性体患者。
就算少量喷洒于食品,也可以放心食用。

一只手40万细菌,清水只能洗掉部分,其他就要消毒洗手液来帮忙了~


生活中难免会出现一些小小的意外,比如在做饭的时候不谨慎被烫到了,孩子好动碰到热水,这时候怎么办?
只用冷水冲一下,或者用偏方救急,最后的结果往往是徒增痛苦,严重的还会重度感染,终生留疤!

冰块冷敷X
温度过低致使已经破损的皮肤伤口恶化。
涂抹牙膏X
牙膏会使皮肤热气无处散发,只能往皮下组织深处扩散,造成更深一层的伤害。
酱油治疗X
首先酱油不具备治疗功能,其次,酱油的颜色会影响医生的诊断。
家中准备一只烫伤膏,可以很大程度应急处理烫伤情况,缓解痛苦和避免终生留疤的风险。

这款药膏对晒伤也一样有效~简直是天气转热必备,安全无副作用,温和不刺激,0激素,0色素,0防腐剂。母婴级安全的最新烫伤修复科技,针对一级二级烧灼伤,更有强效疤痕修复功能。
德国SOS护理套装
德国进口,家庭必备,肆意生活~
¥68 ¥43起


U商城搜索“SOS”,更多好货藏不住!